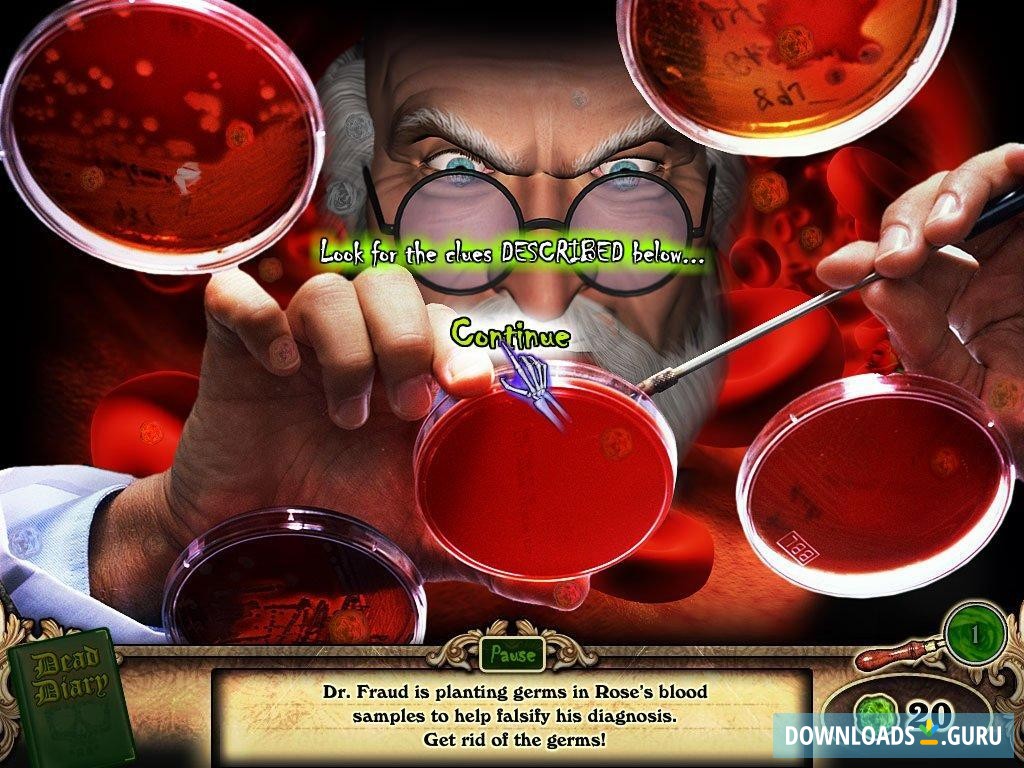
Redrum Dead Diary

- Key features
- Screenshots
- 100% safe download
Download Redrum Dead Diary
Latest version: 2.5.0.35
Developed by
Anarchy Entertainment
License: Shareware
Supported OS: Windows 11/10/8/7
Update date: September 28, 2021
File name: conveyor-chaos_s1_l1_gf6006t1l1_d1255237047.exe (232 KB)
Download Redrum Dead Diary
Comments
You can also post a Facebook comment